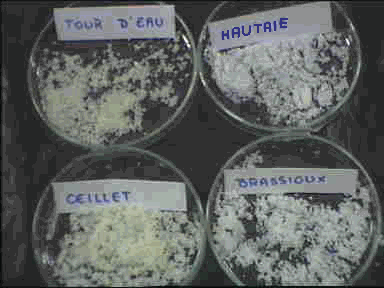

![]()
![]()
![]()
![]()
![]()
![]()
![]()
![]()
![]()
![]()
![]()
![]()
![]()
![]()
![]()
![]()
| La composition de l’eau de mer n’a
pratiquement pas changé depuis 3.5 milliards d’années.
Emprisonnés à l’origine à l’intérieur
de la planète, la vapeur d’eau et d’autres gaz ont fait
irruption à sa surface, créant ainsi l'atmosphère terrestre
au fure et à mesure qu’ils étaient libérés
par le refroidissement du magma. En se condensant , cette eau originale très acide et corrosive , se serait "salée" en dissolvant des éléments superficiels de l ‘écorce terrestre.
Après une visite dans le marais salant,
nous constatons que le sel cristallise, et peut ainsi se récolter,
à partir d’une certaine concentration. Nous allons essayer de
définir cette concentration grâce à des expériences
faites en sciences –expérimentales. |
| Hypothèse
Les cristaux de sel observés dans certains bassins du marais salant: la réserve, le tour d’eau, l’hautaie, les brassioux et les œillets apparaîtraient lors de l’évaporation de l’eau de mer (artificiellement ou naturellement), à partir d’une certaine concentration en Na Cl dont nous allons rechercher la valeur. |
Expérience 1 |
1/ Notre expérience
Afin de produire du sel, nous allons faire bouillir de l’eau de mer.
Nous utiliserons un bêcher rempli de cette eau. Et nous la ferons bouillir à l ‘aide d’un bec bunsen.
Au bout de quelques minutes, l’eau s’étant évaporée nous observons un dépôt blanchâtre au fond du bêcher : du sel.

2/Application à la résolution de notre problème en Biologie
Lors de notre visite au jardin des salines, nous avons prélevé 10 millilitres d’eau dans chacun des bassins du marais (la réserve, le tour d’eau, l’hautaie, les brassioux et les œillets) afin de suivre la concentration en sel lors du trajet de l’eau, de la mer jusqu’au œillets.
Dans le premier bêcher, nous avons mis l’eau de la réserve, dans le deuxième celle du tour d’eau, dans le troisième celle de l’hautaie, dans le quatrième l'eau des brassioux, et enfin dans le cinquième celle des œillets.
Au bout de quelques instants, nous observons que toute l'eau s'est évaporée dans chaque bêcher et qu'il ne reste au fond qu'une substance blanchâtre : Le sel que nous allons peser.

Observé à la loupe

Observé à la loupe

Observé à la loupe
3/ Notre expérience en chimie
Grâce à nos échantillons prélevés lors de la visite au jardin des Salines aux Sables d’Olonne nous allons pouvoir rechercher la concentration dans chaque bassin.
Afin de réaliser cette expérience, nous prélevons 5 cm3 d’eau d'un des bassins. Nous plaçons ensuite cette solution dans une fiole jaugée de 100 cm3, nous remplissons la fiole d'eau distillée afin d'homogénéiser à cela nous rajoutons enfin 1 mL de chromate.
Nous prélevons 2 cm3 de la solution que nous plaçons dans l'erlenmeyer afin de procéder au dosage. Nous versons goutte à goutte du nitrate d'argent jusqu'à obtention d'une coloration rouge.



Tableau des résultats :
| 1
|
2
|
3
|
4
|
5
|
|
NaCl |
175,5g/L | 292,5g/L |
MISE EN
ŒUVRE DES EXPERIENCES II-
1/ Expérience
Nous disposons dans un plateau
à fond noir des boîtes de Pétri numérotées
de 1à 10 contenant chacune une quantité de sel connue ( on
a versé 25 mL d’eau dans chaque boîte et pesé une
certaine quantité de gros sel) :
Le sel s’est dissout dans
l’eau de chaque boîte. Seules 3 boîtes montrent une
différence (boîte 6, 7 et 8).
|
|
2/OBSERVATIONS ET RESULTATS
a) Observation à l’œil nu
Le lendemain, nous constatons que le sel est resté dissout dans plusieurs boîtes de Pétri . Nous observons les cristaux de sel non dissout à l’œil nu dans les boîtes 6,7 et 8 .

zoom
 |
250g/L |
 |
280g/L |
 |
300g/L |
A la loupe binoculaire nous avons l’impression que les cristaux sont différents selon les boîtes. C’est ce qui nous pousse à les observer au microscope.

c) Observation au microscope
Dans les boîtes 4,5 et 6 de
nouveaux cristaux se sont formés après évaporation
d’eau ( 1 semaine après). La concentration a donc augmenté
et a atteint le seuil de cristallisation.
Nous observons les cristaux des
boîtes de Pétri 4,5,6 et 8 au microscope. Il y a deux sortes
de cristaux. Il y a d'une part des cristaux parallélipipédiques
et d'autre part des cristaux pyramidaux .
 |
Exemple de cristaux parallèlépipédiques |
 |
Exemple de cristaux en trémie |
Conclusion : l’hypothèse
est vérifiée, les ions en formant la structure cristalline
sont tombés au fond et nous avons donc constaté que le sel
cristallise pour une concentration supérieur à 250 g/L, comprise
entre 280 et 300 g/L .
CONCLUSION
Au fil de nos expériences
nous avons pu déterminer la concentration en sel dans l'eau
nécessaire à la récolte. En effet nous avons constaté
que pour une concentration s'approchant de 300 g/L des cristaux de sel
apparaissent.
Lorsque l’eau de mer est très
concentrée les ions Na+ et Cl- se lient en grande quantité
constituant un édifice cristallin qui au départ flotte (fleur
de sel) puis devient trop lourd et tombe au fond. Il existe une concentration
optimale pour laquelle les cristaux se forment.
Dans le marais, dans la partie où
la concentration est de 300 g/L (l'œillet), le sel sera récolté
grâce à divers instruments :
La simouche servira à racler
le fond du marais et regrouper les cristaux à un même endroit
et la louse sera utilisée pour ramasser la fleur de sel.

